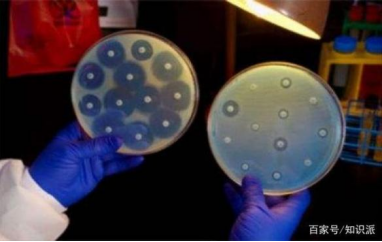

来源:百家号“知识派”(2019-01-10)
你可能没有意识到,在我们平时的生活中,很多东西其实并不是专门为此发明的,而是在偶然的情况甚至是某些事故中意外发现的。喝可乐的吸管?意外发明的;固定鞋子的魔术贴?意外发明的;青霉素?还是一样。虽然我跟大家分享了改变世界的技术发明(可以看我的往期文章),今天我准备了一份比较另类的名单——改变世界的25个意外发明,这些都是在某些时候被无心发明出来的。
25.糖精

你知道比糖还甜的糖精吗?如果我告诉你它是怎么被发现的,你可能会感到很惊讶。1879年,一位试图寻找替代煤焦油的化学家康斯坦丁·法尔伯格(Constantin Fahlberg)在经过一整天的工作后回家吃晚饭,发现他妻子做的饼干比以往要甜一些。 在询问了她之后,他意识到他下班后没有洗手,煤焦油残余物使饼干变甜了。
24.智能微尘

智能微尘(smart dust)是指具有电脑功能的一种超微型传感器,它可以探测周围环境参数,收集数据,进行处理并利用双向无线通信装置传送。它的发现也同样充满“意外”。
对很多大学生来说,在实验室进行试验的过程中发生意外会让人沮丧。但是加州大学的研究生杰米·林克(Jamie Link)充分利用了这种情况,并最终改变了世界。在她研究的硅片意外损毁后,她意识到单个芯片仍然可以用作传感器。如今它们被广泛应用在军事、健康监控、环境监控、医疗等诸多领域。
23.薯片

1853年,纽约厨师乔治·克鲁姆(George Crum)意外地发明了薯片。当时一个烦人的顾客因为感觉他的法式炸土豆不好吃一次又一次退回厨房。为了给顾客一个教训,Crum将它们切成薄片并油炸酥脆后浸在盐中。然而,令他惊讶的是,这位顾客竟然喜欢上了这种味道。
22.可口可乐

可口可乐的发明现在可能是众所周知的事情了,但是如果没有内战老兵美国药剂师约翰·彭伯顿(John Pemberton)因意外发明出的可口可乐,相信它也不会出现在我们的清单中。他最初的打算仅仅是治疗几种疾病的药物,比如鸦片成瘾和胃部不适,却机缘巧合的发明了世界上最受欢迎的饮料之一。这也是为什么最初的可口可乐确实在其成分列表中包含可卡因的原因。
21.冰棒

1905年,苏打汽水刚刚成为市场上最受欢迎的饮料。11岁的弗兰克·埃珀森(Frank Epperson)为了节省家用决定自己在家做点什么来赚钱。他用一些食用粉末和水混合搅拌在一起感觉差不多了就放在门口,做完以后他就把这事抛在脑后,一晚上的时间屋外温度早已经降到0℃以下,等第二天他想起来时发现他的“作品”早就和搅拌棒冻在了一起。
20.冰淇淋甜筒

虽然冰淇淋已经出现了很久很久,但是直到1904年世界博览会,冰淇淋甜筒才真正的诞生。因为集市上的一个冰淇淋摊的生意非常好,以至于撑冰淇淋的盘子很快用完了。而旁边卖华夫饼的摊位几乎没有什么生意,两个摊主一合计想到将华夫饼卷起来然后把冰淇淋放在上面,你瞧!冰淇淋甜筒就是这么诞生的!
19.特氟隆(不粘锅涂层材料)

如果你用不粘锅做过东西你会发现不粘锅真是一个神奇的发明,当然你更应该感谢罗伊·普兰科特(Roy Plunkett)。他是一名化学家,20世纪初为杜邦公司工作。他在实验制冷剂的过程中意外地发现了一种无反应、无粘性的化学物质。杜邦公司知道后很快就申请了专利,就是我们今天所说的特氟隆,它可以防止你在做饭的时候粘锅。
18.硫化橡胶

查尔斯·古德伊尔(Charles Goodyear)花了很长时间试图找到一种使橡胶耐热耐寒的方法。经过多次失败的尝试后,他在一次偶然的机会中发现了一种混合物。一天晚上熄灯前,他不小心把橡胶、硫磺和铅洒到了炉子上,导致混合物烧焦变硬,这就是我们现在广泛用于轮胎和鞋底的东西。
17.塑料

在1900年代早期,虫胶是绝缘材料的首选,但由于它是由产自东南亚的甲虫为原料制成的,因此进口价格并不便宜。 出于这个原因,化学家Leo Hendrik Baekeland认为他可以通过生产虫胶的替代品来赚钱。然而,他想出的却是一种可模塑的材料,可以在高温下不变形,也称为塑料,这也是人类历史上第一种完全人工合成的塑料。
16.放射性

1896年,物理学家亨利·贝克勒尔(Henri Becquerel)试图让荧光物质留在太阳下产生X射线。然而天公不作美,正准备试验的时候迎来了一周的多云天气,无奈之下他只好把所有的材料都放在抽屉里。一周后他突然发现,他留在那里的铀盐在没有光照的情况下成功地在照相板上印下了图像。
15.苯胺紫

还有更神奇的,就在18岁的化学家威廉·珀金(William Perkin)忙于研究疟疾的治疗方法时,他一不小心改变了世界时尚界。那一年是1856年,他的一项实验结果出了严重的问题,造成了一片混乱。然而当他检查实验时,威廉突然发现培养皿中散发出一种美丽的颜色。因此,他成功的发明了世界上第一种合成染料,并向世界展现了紫色。
14.起搏器

Wilson Greatbatch当时正在研究一种装置,当他不小心把错误的电阻插入装置后,却惊奇的发现这种装置可以记录人类的心跳。它最终完美地模仿了心率,并创造了第一个植入式起搏器。
13.便利贴

1968年,为3M公司工作的化学家Spencer Silver偶然发现了一种“低粘性”粘合剂,他发现这种粘合剂的强度足以将纸张固定在表面上,但又足够薄可以方便的撕下来。在尝试了许多可能的应用场景后,Silver的一位同事Art Fry意识到它也许将是一个完美的防滑书签,于是便利贴就这么诞生了。
12.微波

我想每个厨师或是不爱做饭的我们都应该感谢海军雷达专家Percy Spencer。当他正在维修微波发射器时,偶然间发现口袋里的巧克力棒正在逐渐融化。这一年是1945年,世界,或者更确切地说是厨房,从那时起就不一样了。
11.Slinky(机灵鬼)

在第二次世界大战期间,海军工程师理查德·詹姆斯(Richard James)想找到一种弹簧装在海军船只上的敏感仪器上,这样在他们发生意外掉落时通过来回跳动来缓冲不至于损坏。令人啼笑皆非的是,他发明的这种弹簧在掉落后立马恢复了原状,笔直地落在了地板上。从那时起,世界各地的孩子们都喜欢上了这种有弹性的玩具。
10.橡皮泥

毫无疑问几十年来,橡皮泥一直是孩子们最喜爱的玩具之一。但是这种东西最初被发明是用来清洁墙纸的。然而在20世纪初,西方逐渐停止使用煤炭来取暖,这意味着他们的墙纸相对保持了干净。幸运的是,橡皮泥的发明家克莱奥·麦克维克(Cleo McVicker)发现了它的另一种用途——粘土建模。
9.强力胶

柯达实验室的研究人员哈里·库弗(Harry Coover)在开发枪支瞄准镜用塑料透镜时偶然发现了一种由氰基丙烯酸酯制成的合成粘合剂。当时他认为这玩意儿它太粘了,根本没有任何用处。多年以后,它被“重新发现”并更名为“强力胶”在商店里出售。
8.魔术贴

1948年,瑞士工程师乔治·德·梅斯特拉(George de Mestral)带着他的狗去打猎,并在途中偶遇牛蒡芒刺。这是一种包裹在上百个“钩子”中的小种子,这些钩子能够自然钩住毛皮、毛发和服装表面的微小搭扣。这引发了他的好奇心,通过显微镜的进一步观察,他发现了其中的奥秘:原来苍耳每个刺的顶端结构都是一个小钩子,就是这种结构使它可以轻易的钩在有毛圈结构的裤料上。
最终,他成功在实验室里复制了这种效果,但是直到20世纪60年代美国航天局在太空项目中使用这种材料之后这种“魔术贴”才真正开始普及。
7.X射线

1895年11月8日傍晚,威廉·伦琴用阴极射线进行了一项实验。为了防止外界光线对放电管的影响,他把房间全部弄黑。可是当他切断电源后,却意外地发现一米以外的一荧光屏有闪光,而这绝非阴极射线造成的,经过反复实验,他确信这是种尚未为人所知的新射线,便取名为X射线。
6.安全玻璃

法国化学家爱德华·贝内迪克特斯(douard Bénédictus)有一天不小心从桌子碰倒了一个烧瓶。但烧瓶掉在地上并没有碎裂,只是裂开了。随后他发现烧瓶中的塑料硝酸纤维素已经蒸发并在烧瓶内部留下了一层薄而耐用的薄膜。这使得贝内迪克特斯获得了安全玻璃的第一个专利,这也是最常用于汽车挡风玻璃的专利。
5.玉米片

美国医学博士维尔·凯斯·凯洛格(Will Keith Kellogg)在养老院帮助他哥哥做饭时,看到一些被放置了几小时的用来做面包的面团,决定把它们烘焙一下,于是就产生了第一批玉米片。
4.炸药

炸药源于我国。至迟在唐代,我国已发明火药(黑色炸药),这是世界上最早的炸药。威力较大的黄色炸药源于瑞典。由瑞典化学家、工程师和实业家诺贝尔发明。在这之前火药和硝化甘油已经存在很久了。然而,问题在于它的不稳定性,尤其是硝化甘油。在一次实验中诺贝尔偶然发现,硝化甘油可被干燥的硅藻土所吸附,这种混合物可安全运输。最终他成功研制出性能可靠的黄色炸药,硅藻土炸药。
3.麻醉

麻醉最早可追溯到人类历史最古老的石器时代,之后各国都有应用麻醉的记载,我们要说的是一氧化二氮又名笑气的药物。笑气最初的目的是用来娱乐,它有一种微甜的令人愉快的奇特气味,被人吸入后,能使人的敏感度降低,迅速陷于沉醉状态,跳出美妙的舞姿,说些荒谬的梦话,让目睹者捧腹大笑,所以又叫“笑气”。最终,外科医生开始在手术过程中开始使用乙醚,为我们今天在手术中使用的现代麻醉剂铺平了道路。
2.不锈钢

下次在使用不锈钢餐具的时候我们应该记得感谢英国冶金学家Harry Brearly,20世纪武器制造商雇用Harry Brearly想要开发一种不会生锈的枪管。他在发明这种材料并进行各种腐蚀剂(如柠檬汁)测试后,突然意识到不锈钢将是制作餐具的完美材料。
1.青霉素
在研究葡萄球菌的过程中,微生物学家亚历山大·弗莱明(Alexander Fleming)在去度假前将一些细菌添加到培养皿中。他原以为细菌会生长,但回来后,他惊讶地发现一个培养皿被霉菌污染了,霉菌周围一圈的葡萄球菌都被杀死。经过仔细的研究发现,霉菌可以释放出一种抑制葡萄球菌生长的物质,由此产生了第一种抗生素——青霉素。

